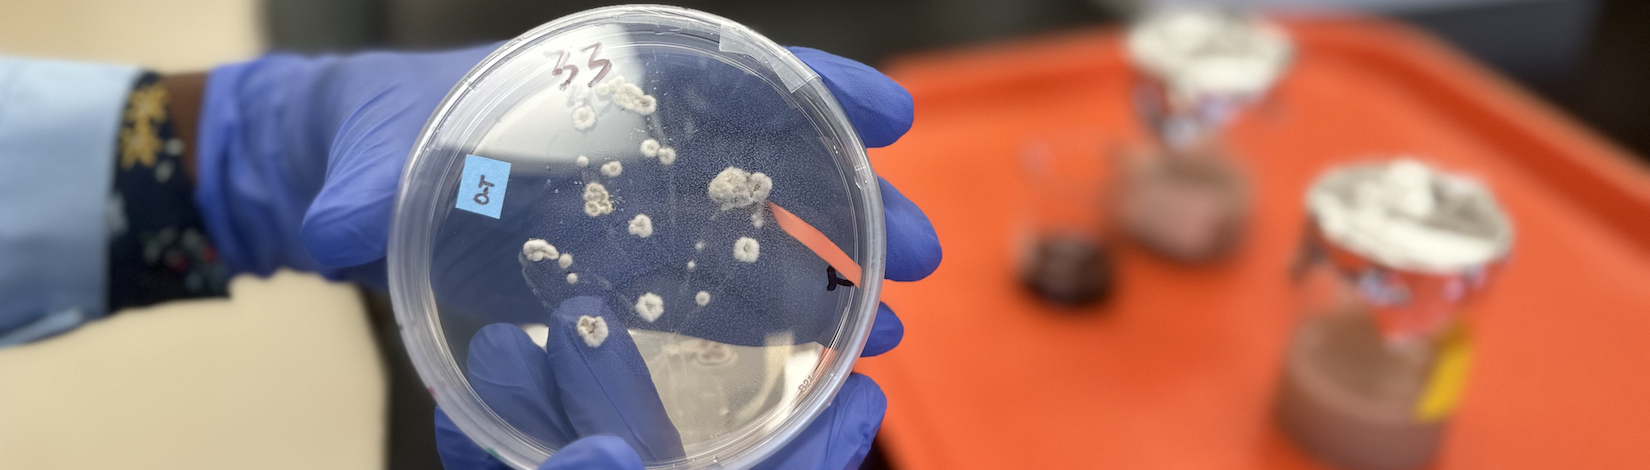

Agricultural leader honored by National FFA Organization
November 5, 2024
FORT PIERCE, Fla.---Mark Kistler, a Florida native and seasoned leader in stakeholder relations and agricultural education, was recently honored with an Honorary American FFA Degree during the 97th National FFA Convention & Expo held ... READ MORE
Category: 4-H & Youth, Professional DevelopmentTags: #DrMarkKistler, #FFA, #FFAHonoraryDegree, #UFIFASIRREC